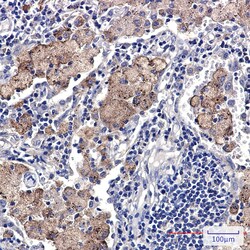
Invitrogen SMN1 Recombinant Rabbit Monoclonal Antibody (K01_1R60) 100 &mu;L | Buy Online | Invitrogen&trade; | Fisher Scientific

missing translation for 'onlineSavingsMsg'
Learn More
Learn More
Invitrogen™ SMN1 Recombinant Rabbit Monoclonal Antibody (K01_1R60)


Description
SMN1 Recombinant Monoclonal Antibody for IHC (P), Western Blot
The SMN1 gene is part of a 500 kb inverted duplication on chromosome 5q13. This duplicated region contains at least four genes and repetitive elements which make it prone to rearrangements and deletions. The repetitiveness and complexity of the sequence have also caused difficulty in determining the organization of this genomic region. The telomeric and centromeric copies of this gene are nearly identical and encode the same protein - survival motor neuron protein. The SMN complex plays a catalyst role in the assemble of small nuclear ribonucleoproteins, the building blocks of the spliceosome. Mutations in the SMN1 gene are known to cause spinal muscular atrophy 1/2.

Specifications
Specifications
| Antigen | SMN1 |
| Applications | Immunohistochemistry (Paraffin), Western Blot |
| Classification | Recombinant Monoclonal |
| Clone | K01_1R60 |
| Concentration | 1 mg/mL |
| Conjugate | Unconjugated |
| Formulation | 50mM tris glycine with 150mM NaCl, 0.05% BSA, 40% glycerol and 0.01% sodium azide; pH 7.4 |
| Gene | SMN1 |
| Gene Accession No. | Q16637 |
| Gene Alias | AI849087; BCD541; component of gems 1; Gemin1; Gemin-1; SMA; SMA@; SMA1; SMA2; SMA3; SMA4; Smn; SMN1; SMN2; SMNC; SMNT; survival motor neuron 1; survival motor neuron 1 protein; survival motor neuron protein; survival of motor neuron 1, telomeric; survival of motor neuron protein; T-BCD541; TDRD16A; tudor domain containing 16A |
| Show More |
Product Title
By clicking Submit, you acknowledge that you may be contacted by Fisher Scientific in regards to the feedback you have provided in this form. We will not share your information for any other purposes. All contact information provided shall also be maintained in accordance with our Privacy Policy.
Spot an opportunity for improvement?